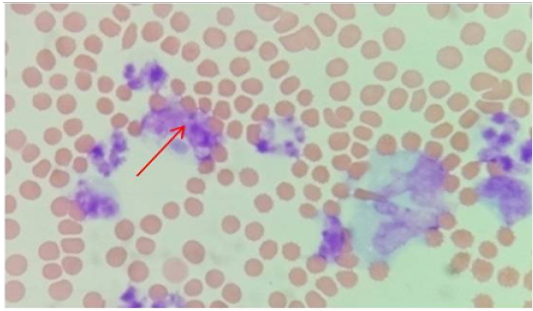

Research Journal for Veterinary Practitioners
Case Report
Res. J. Vet. Pract. 5(4): 37-39
Figure 1
Showing nasal bleeding
Figure 2
Showing haemorrhage on the back
Figure 3
Showing Ehrlichia Canis Morulae in monocytes